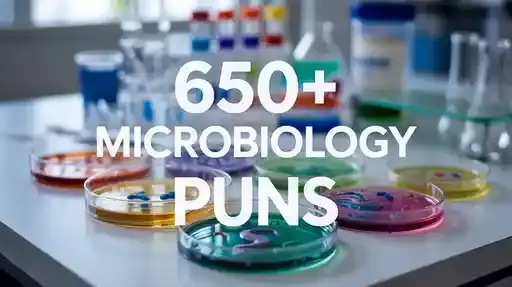

Love, friendship, and care are the invisible threads that bind our lives, much like the tiniest microbes shaping our world in ways we often overlook. Just as a wedding anniversary celebrates years of shared laughter, support, and growth, the microscopic universe reminds us that even the smallest connections can create profound joy.
Today, we dive into a delightful collection of Microbiology Puns, Jokes, and One-Liners designed to bring smiles, giggles, and heartwarming amusement to every lover of science.
Whether you are a student, teacher, or simply curious about the microscopic world, these playful quips will tickle your funny bone while celebrating the bonds we share.
Hilarious Microbiology Humor for Science Lovers

- Bacteria never argue because they always divide peacefully 🦠.
- Viruses are great at parties because they always know how to replicate the fun 🧬.
- Microbes may be small, but their impact is huge 🌱.
- Fungi are the best comedians; they always spore laughter 🍄.
- Amoebas are terrible at relationships because they keep changing forms 🌀.
- Prokaryotes know how to stay simple and happy 🧫.
- Yeast are the life of the fermentation party 🍞.
- Parasites are clingy friends nobody wants 🐛.
- Microbiology jokes are cell-tastic for your soul 🧪.
- Antibiotics can’t fix a broken heart 💔.
- Viruses always bring a little chaos to the table ⚡.
- Petri dishes are perfect places for microbial networking 🥼.
- Some bacteria like to keep things culture-rich 🎨.
- Cells have the ultimate power of division and collaboration ⚛️.
- Microbes remind us that even tiny things can create a world of joy 🌎.
Fun Microbial One-Liners to Brighten Your Day
- E. coli might be naughty, but it keeps life interesting 🧬.
- Protozoa always know how to move with grace 🌀.
- Microbes throw the best microscopic parties 🎉.
- Bacteria are never lonely because they always stick together 🦠.
- Fungi know how to grow with style 🍄.
- Viruses are sneaky, but they make excellent plot twists 🧫.
- Cells are masters of organization and teamwork ⚛️.
- Amoebas are nature’s shapeshifters 🔄.
- Yeast know how to rise to any occasion 🍞.
- Petri dishes are tiny worlds full of surprises 🥼.
- Microbiology humor is contagious in the best way 😂.
- Antibiotics are the ultimate problem solvers 💊.
- Protozoa remind us to stay flexible and adapt 🌊.
- Microbes prove that size doesn’t limit impact 🌱.
- Cells celebrate life with every division ⚡.
Clever Microbiology Jokes for Students

- Why did the bacterium go to therapy? It had a lot of unresolved cell issues 🧬.
- What do you call a fun virus? A party-phage 🦠.
- How do fungi celebrate birthdays? They have a spore-tacular time 🍄.
- Why are amoebas bad at math? They always multiply randomly 🔢.
- What do prokaryotes say at the gym? Keep your cell strong 💪.
- Why did the yeast break up with bacteria? It needed more space 🍞.
- How do antibiotics stay in shape? By running culture experiments 🧫.
- Why did the virus join a band? It loves to spread the rhythm 🎶.
- How do cells throw a party? With lots of division ⚛️.
- Why did the fungus get invited to every event? It’s always a fun-gi 🍄.
- What’s a microbe’s favorite game? Hide and spore 🥼.
- Why don’t bacteria ever get bored? They keep splitting and evolving 🔄.
- How do protozoa text each other? With cell signals 📱.
- Why are viruses so dramatic? They love a little replication theater 🎭.
- What did the microbiologist say to the petri dish? You complete me 🦠.
Cute Microbiology Wordplay for Teachers
- Cells are like students; they love guidance and a little division ⚛️.
- Microbes teach us that even the smallest effort matters 🧬.
- Fungi remind us to be flexible and spore our potential 🍄.
- Viruses show the importance of timing in life 🕰️.
- Yeast inspires us to rise even in tough situations 🍞.
- Bacteria teach teamwork through simple living 🦠.
- Amoebas show adaptability is key 🔄.
- Antibiotics remind us that solutions exist for hard problems 💊.
- Petri dishes are classrooms for microscopic wonders 🥼.
- Protozoa exemplify movement and change 🌊.
- Microbiology puns make lessons unforgettable 😂.
- Cells demonstrate how small actions create big results ⚡.
- Microbes inspire curiosity and joy 🌱.
- Viruses emphasize caution with a dash of fun 🧫.
- Microbial humor makes learning a heartwarming experience ❤️.
Light-Hearted Microbial Laughs

- E. coli may be mischief, but it teaches resilience 🧬.
- Amoebas always keep things interesting with shape shifts 🔄.
- Yeast rise to the occasion every single time 🍞.
- Fungi grow on positivity and laughter 🍄.
- Viruses show the art of spreading joy carefully 🦠.
- Cells divide responsibilities to stay organized ⚛️.
- Microbiology jokes create tiny sparks of happiness 🌟.
- Antibiotics remind us to take care of what matters 💊.
- Protozoa glide through challenges with ease 🌊.
- Petri dishes showcase miniature worlds full of magic 🥼.
- Microbes demonstrate that everyone can make a difference 🌱.
- Bacteria know how to stick with friends 🧫.
- Viruses add a little twist to life ⚡.
- Amoebas teach us adaptability is everything 🔄.
- Fungi remind us to enjoy the growth journey 🍄.
Infectious Laughter with Microbiology
- Microbes are proof that even the tiniest things matter 🌱.
- Viruses love dramatic entrances and exits ⚡.
- Yeast makes every party rise to the occasion 🍞.
- Amoebas keep life unpredictable and fun 🔄.
- Bacteria thrive when they stick together 🦠.
- Fungi always find a way to pop up 🍄.
- Cells show how division creates beauty ⚛️.
- Microbiology puns spread smiles faster than germs 😂.
- Antibiotics remind us to take action when needed 💊.
- Protozoa show flexibility keeps life moving 🌊.
- Petri dishes are tiny stages for big experiments 🥼.
- Viruses teach caution with a playful twist 🧫.
- Microbes prove that size is no measure of impact 🌱.
- Amoebas exemplify personal growth through change 🔄.
- Fungi remind us that fun is always part of life 🍄.
Wholesome Microbiology Jokes for Everyone

- Cells celebrate life with every split ⚛️.
- Viruses love spreading joy and excitement 🦠.
- Yeast proves rising up takes patience 🍞.
- Bacteria teach harmony through simple coexistence 🧬.
- Amoebas inspire adaptability in all situations 🔄.
- Fungi remind us that growth is beautiful 🍄.
- Microbiology humor connects hearts with laughter ❤️.
- Antibiotics emphasize problem-solving 💊.
- Protozoa show movement brings opportunities 🌊.
- Petri dishes create safe spaces for exploration 🥼.
- Microbes show curiosity leads to discovery 🌱.
- Cells exemplify teamwork and unity ⚛️.
- Viruses prove even tricky situations can be fun ⚡.
- Amoebas remind us to embrace change 🔄.
- Fungi teach patience and persistence 🍄.
Microbial Puns That Make You Smile
- Why did the bacteria get promoted? It showed outstanding cell-flection 🧬.
- Amoebas are flexible friends 🔄.
- Yeast is proof you can always rise again 🍞.
- Fungi always have fun at parties 🍄.
- Viruses love a little mischief ⚡.
- Cells make teamwork look effortless ⚛️.
- Microbiology jokes create contagious happiness 😂.
- Antibiotics are the problem solvers 💊.
- Protozoa keep moving gracefully 🌊.
- Petri dishes are worlds of tiny wonders 🥼.
- Microbes remind us that even the smallest actions matter 🌱.
- Bacteria show the power of sticking together 🦠.
- Viruses teach us the art of timing 🧫.
- Amoebas inspire personal growth 🔄.
- Fungi prove that fun is essential 🍄.
Laughing Through the Lens of Microbiology

- Cells celebrate division and collaboration ⚛️.
- Viruses love dramatic replication ⚡.
- Yeast rise to challenges every day 🍞.
- Amoebas exemplify flexibility 🔄.
- Bacteria stick together for success 🦠.
- Fungi grow on positivity 🍄.
- Microbiology humor is universally heartwarming ❤️.
- Antibiotics remind us to act wisely 💊.
- Protozoa move with effortless grace 🌊.
- Petri dishes showcase miniature miracles 🥼.
- Microbes prove small things have huge impact 🌱.
- Cells demonstrate teamwork pays off ⚛️.
- Viruses add fun twists to life 🧫.
- Amoebas teach adaptability 🔄.
- Fungi remind us joy comes with growth 🍄.
Microbiology Comedy That Clicks
- Why did the bacterium cross the microscope? To get to the other slide 🦠.
- Amoebas love to change shapes 🔄.
- Yeast always rises to the occasion 🍞.
- Fungi bring spore-tacular fun 🍄.
- Viruses add a little chaos and excitement ⚡.
- Cells know how to divide and conquer ⚛️.
- Microbiology puns spread smiles naturally 😂.
- Antibiotics solve problems quickly 💊.
- Protozoa show effortless movement 🌊.
- Petri dishes hold magical miniature worlds 🥼.
- Microbes remind us that small actions matter 🌱.
- Bacteria show loyalty and togetherness 🧫.
- Viruses love to spread laughter ⚡.
- Amoebas demonstrate personal growth 🔄.
- Fungi remind us fun is essential 🍄.
Tiny Life, Big Laughs

- Cells teach collaboration and unity ⚛️.
- Viruses enjoy dramatic entrances ⚡.
- Yeast rises above challenges 🍞.
- Amoebas keep life unpredictable 🔄.
- Bacteria thrive together 🦠.
- Fungi grow in fun ways 🍄.
- Microbiology humor warms the heart ❤️.
- Antibiotics provide solutions 💊.
- Protozoa show the power of movement 🌊.
- Petri dishes showcase miniature wonders 🥼.
- Microbes prove even small things matter 🌱.
- Cells make teamwork look effortless ⚛️.
- Viruses add unexpected twists 🧫.
- Amoebas teach flexibility 🔄.
- Fungi remind us to enjoy the growth journey 🍄.
Microbial Wordplay That Tickles
- Why did the virus bring a suitcase? It was on a replication trip ⚡.
- Amoebas always keep things interesting 🔄.
- Yeast makes life rise to every occasion 🍞.
- Fungi know how to spread fun 🍄.
- Bacteria stick to their friends 🦠.
- Cells demonstrate perfect division ⚛️.
- Microbiology jokes spread joy instantly 😂.
- Antibiotics remind us to take action 💊.
- Protozoa glide through challenges 🌊.
- Petri dishes hold countless tiny stories 🥼.
- Microbes prove that small efforts matter 🌱.
- Viruses teach timing is everything 🧫.
- Amoebas exemplify change and adaptability 🔄.
- Fungi remind us that patience brings rewards 🍄.
- Microbiology humor creates warm connections ❤️.
Playful Microbe Jokes

- Why was the bacterium so calm? It had great cell control 🧬.
- Amoebas love to improvise 🔄.
- Yeast rises above the rest 🍞.
- Fungi bring laughter everywhere 🍄.
- Viruses like dramatic flair ⚡.
- Cells know how to work together ⚛️.
- Microbiology puns are infectious in the best way 😂.
- Antibiotics solve problems effectively 💊.
- Protozoa move with ease 🌊.
- Petri dishes are tiny playgrounds for microbes 🥼.
- Microbes remind us that small things create big change 🌱.
- Bacteria thrive in togetherness 🦠.
- Viruses show timing can be fun 🧫.
- Amoebas inspire flexibility 🔄.
- Fungi teach the value of growth 🍄.
Conclusion: The Heart of Microbial Laughter
Microbiology is more than science; it is a reminder that even the tiniest life forms hold immense lessons about growth, adaptability, teamwork, and joy.
Just like cherished friendships and loving relationships, microbes show us that connection, persistence, and a touch of humor make life truly beautiful.
Let these jokes, puns, and one-liners inspire you to laugh, bond, and celebrate the microscopic wonders that mirror our own human experiences.
FAQ Section
1. What are microbiology puns one-liner?
Microbiology puns one-liner are short, witty jokes or wordplays based on microbes, cells, bacteria, viruses, and fungi that create humor and make science fun.
2. Why are microbiology jokes important?
They make learning enjoyable, help students remember complex concepts, and add a fun, lighthearted approach to scientific topics.
3. Can microbiology humor be used in classrooms?
Yes, teachers use these jokes to engage students, encourage participation, and make science more memorable and relatable.
4. Are microbiology one-liners suitable for social media?
Absolutely, they are perfect for social media posts, memes, and fun educational content that can go viral while being informative.
5. How do microbiology puns improve understanding of science?
By connecting humor with concepts, they help learners visualize processes, remember terminology, and foster curiosity in a relaxed and enjoyable way.

Lily is a copywriter and pun lover who enjoys exploring how words shape meaning and tone. Her writing style is crisp, clear, and often sprinkled with humor. She joined Puns Haha to make grammar learning enjoyable for everyone — from beginners to word nerds.